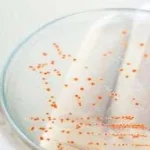
Kebiasaan Pinjamkan 5 Barang Ini Harus Dihilangkan Demi Kesehatan ilustrasi pinjam barang

Direktur Polairud Beber Prestasi Sepanjang Tahun 2016
ZONASULTRA.COM,KENDARI- Upacara Hari Ulang Tahun (HUT) Kepolisian Perairan dan Kepolisian Udara (Polairud) yang ke-66 Polda Sultra dilaksanakan pagi ini di lapangan apel Polda Sultra...
Tidak Memiliki Izin Operasi, DPRD Sultra Warning Tutup PT Semen Tonasa
ZONASULTRA.COM, KENDARI - Dewan Perwakilan Rakyat Daerah (DPRD) Sulawesi Tenggara (Sultra) mengancam akan menutup PT Semen Tonasa di Kelurahan Lapuko Kecamatan Moramo, Kabupaten Konawe...
Dinkes Konut Musnahkan Obat Kadaluarsa
ZONASULTRA.COM, WANGGUDU - Dinas Kesehatan Kabupaten Konawe Utara (Konut) Sulawesi Tenggara (Sultra) bersama Badan Pengawasan Daerah (Bawasda) juga Sektor Kepolisian Asera, melakukan pemusnahan ratusan...
Ini Alasan Anak-Anak Dilarang Menggunakan Kawat Gigi
ZONASULTRA.COM, KENDARI - Anak usia di bawah 14 tahun dianjurkan untuk tidak memakai kawat gigi (Brances). Menurut drg. Dian Fatmawati, anak umur 14 tahun...
Penetapan Perda OPD Terlambat, KUA/PPAS Mubar Belum Dibahas
ZONASULTRA.COM, LAWORO - Terlambatnya penetapan peraturan daerah (Perda) tentang Organisasi Perangkat Daerah (OPD) ternyata berimplikasi pada proses pembahasan Kebijakan Umum Anggaran/Prioritas Plafon Anggaran Sementara...
Mahasiswa Demo di DPRD Sultra Tolak Plt Rektor UHO
ZONASULTRA.COM, KENDARI - Puluhan mahasiswa yang tergabung dalam Barisan Pemuda Pemerhati Universitas Halu Oleo (BPP UHO) berunjuk rasa di DPRD Sultra, Rabu (30/11/2016) menolak...
Ketua FKUB Sultra Himbau Masyarakat Menahan Diri Terkait Rencana Aksi 212
ZONASULTRA.CO, KENDARI- Demonstrasi lanjutan dari aksi 411 atau 4 November rencananya akan dilakukan pada 2 Desember (212) mendatang dengan agenda dan tuntutan yang sama,...
DPRD Sultra Cari Pembanding di Daerah Lain Untuk Anggaran Pilgub
ZONASULTRA.COM, KENDARI - Pemerintah Provinsi (Pemprov) Sulawesi Tenggara (Sultra) dan KPUD Sultra, telah menyepakati anggaran Pemilihan Gubernur (Pilgub) 2018 dalam dua kali penganggaran, melalui...
BMKG : Berita Dunia Akan Dilanda Kemarau Panjang 2019-2022 Hoax
ZONASULTRA.COM, KENDARI - Belakangan ini, penduduk dunia digegerkan dengan berita yang mengatakan Dunia akan dilanda kemarau panjang pada 2019-2022.Hal ini sontak saja dibantah oleh...
Antisipasi Bencana, KNPI Sultra Gelar Pelatihan SKS
ZONASULTRA.COM, KENDARI - Komite Nasional Pemuda Indonesia (KNPI) Sulawesi Tenggara (Sultra) menggelar pelatihan Shelter Kampung Siaga (SKS), di Hotel Minah Kendari, Rabu (30/11/2016). Kegiatan...
Pemprov Sultra Gelar Doa Bersama Lintas Agama untuk NKRI
ZONASULTRA.COM, KENDARI- Pemerintah Provinsi Sulawesi Tenggara (Sultra) bersama Kantor Wilayah (Kanwil) Kemenag Sultra dan TNI beserta Polri menggelar kegiatan doa bersama lintas agama untuk...
Ini 5 Kebiasaan Buruk yang Merusak Tubuh, Namun Kerap Dilakoni
ZONASULTRA.COM - Banyak sederet kebiasaan yang seringkali dilakoni oleh diri sendiri, di mana pada akhirnya kebiasaan buruk ini dapat mendatangkan efek negatif pada tampilan...
Jelang Natal dan Tahun Baru, Stok Pangan di Kendari Aman
ZONASULTRA.COM, KENDARI - Persediaan stok pangan di Kota Kendari, Sulawesi Tenggara (Sultra) menjelang Natal dan Tahun Baru 2017 terpantau aman dan stabil.Kepala Bidang Perdagangan...
Raperda OPD Mubar Kembali Dibahas oleh DPRD
ZONASULTRA.COM,LAWORO-Setelah mendapatkan evaluasi dari Pemerintah Provinsi, Rancangan Peraturan Daerah (Raperda) Organisasi Perangkat Daerah (OPD) akan kembali dibahas oleh Dewan Perwakilan Rakyat Daerah (DPRD) Kabupaten...
Pemprov Sultra Deteksi Pungli Terbesar ada di Dispenda
ZONASULTRA.COM, KENDARI – Pemerintah Provinsi (Pemprov) Sulawesi Tenggara (Sultra) mulai mendeteksi adanya pungutan liar (pungli) di dinas provinsi. Pendeteksian tersebut dilakukan dengan menurunkan tim...
Ditlantas Polda Sultra Launching Regident Centre Berbasis Android, Ini Manfaatnya
ZONASULTRA.COM, KENDARI- Kepolisian Daerah (Polda) Sulawesi Tenggara (Sultra) resmi melaunching program Regident Centre (RC) Ditlantas Polda Sultra di aula Ditlantas, Selasa (29/11/2016).Kapolda Sultra Brigjen...
Kebiasaan Pinjamkan 5 Barang Ini Harus Dihilangkan Demi Kesehatan
ZONASULTRA. COM - Sejak kecil kebanyakan dari kita, mungkin diajari untuk saling berbagi membantu sesama. Mulai dari mainan, peralatan, hingga uang semua bisa kita...
Ini Tanggapan Kepala Bandara Halu Oleo Terkait Keluhan Kekurangan Kursi di Bandara
ZONASULTRA.COM, KENDARI - Kepala Bandara Halu Oleo Kolonel Pnb. Sarmanto angkat bicara mengenai keluhan penumpang terkait kurangnya kursi di ruang tunggu bandara.Menurut Sarmanto, yang...
8 PNS Terbukti Ijazah Palsu, Pemprov Sultra Tak Lakukan Pemecatan
ZONASULTRA.COM, KENDARI – Pegawai Negeri Sipil (PNS) pengguna ijazah palsu lingkup Pemerintah Provinsi (pemprov) Sulawesi Tenggara (Sultra) yang berjumlah 8 orang batal diumumkan dalam...
Nur Alam Mendadak Marah-Marah di Upacara HUT Korpri 45
ZONASULTRA.COM, KENDARI –Gubernur Sulawesi Tenggara (Sultra) Nur Alam dibuat kesal ketika memimpin upacara Hari Ulang Tahun (HUT) Korpri ke-45 di Halaman Kantor Gubernur Sulawesi...